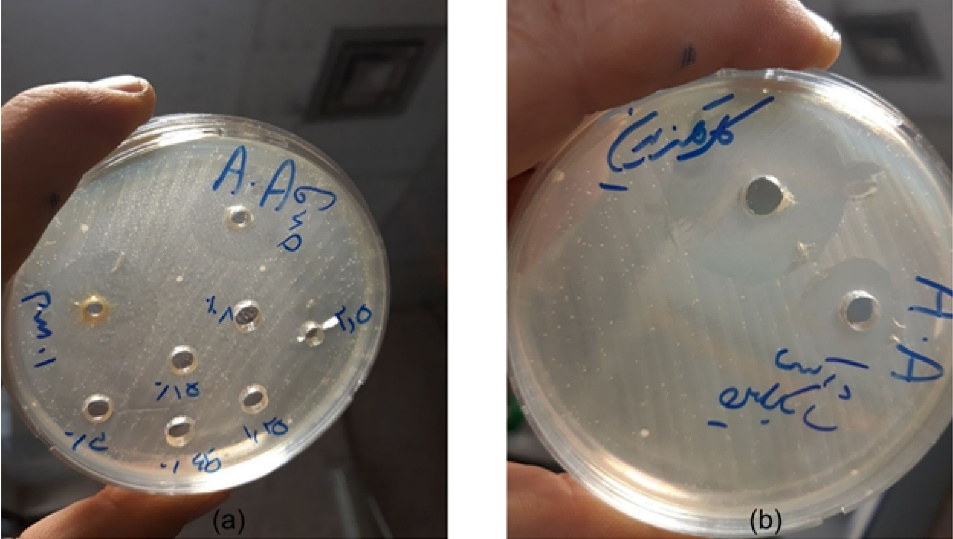
japid-15-35-g002

J Adv Periodontol Implant Dent. 15(1):35-41.
doi: 10.34172/japid.2023.006
Research Article
Evaluation of the antibacterial effect of hydroalcoholic extract of the galls of Quercus infectoria on Aggregatibacter actinomycetemcomitans
Zohreh Tabibzadeh Noori Methodology, Project administration, Writing – review & editing, 1 
Mohadese Tabatabaei Rad Formal analysis, Funding acquisition, Visualization, Writing – original draft, 2, * 
Mojdeh Hakemi Vala Data curation, Investigation, Supervision, Validation, Writing – review & editing, 3
Mehrdad Karimi Investigation, Writing – review & editing, 4
Azadeh Esmaeil Nejad Conceptualization, Writing – review & editing, 1
Author information:
1Department of Periodontics, School of Dentistry, Shahid Beheshti University of Medical Science, Tehran, Iran
2Department of Pediatrics, School of Dentistry, Kerman University of Medical Sciences, Kerman, Iran
3Department of Microbiology, Faculty of Medicine, Shahid Beheshti University of Medical Science, Tehran, Iran
4Faculty of Traditional Medicine, Tehran University of Medical Science, Tehran, Iran
Abstract
Background.
Aggregatibacter actinomycetemcomitans (Aa) plays a vital role in some destructive forms of periodontitis. While mechanical and chemical plaque control is the first step in periodontitis treatment, side effects of adjunctive chemical agents such as chlorhexidine (CHX) mouthwash have led to the application of natural alternatives with minimal side effects. Therefore, this study evaluated the antibacterial effect of the hydroalcoholic extract of Quercus infectoria (Qi) galls on Aa in vitro.
Methods.
The hydroalcoholic extract of Qi was obtained by the maceration method, and Aa bacterial strain was cultured. The inhibition zone diameter was measured through the agar well diffusion method. Also, the minimum inhibitory concentration (MIC) and minimum bactericidal concentration (MBC) values were determined by the broth microdilution method. All the experiments were repeated three times. 0.2% CHX was used as a control.
Results.
The inhibition zone diameter of Aa increased with increasing concentration of Qi extract. While MIC and MBC values for CHX were 0.0039 and 0.0078 mg/mL, respectively, both MIC and MBC values of the Qi extract for this bacterium were similar, i.e., 2.5 mg/mL, which was significantly higherd.
Conclusion.
Since other in vivo studies have confirmed the other properties of this extract and its safety in terms of cytotoxicity and mutagenicity, hydroalcoholic extract of Qi may be used in mouthwashes or local delivery systems to affect periodontal biofilm.
Keywords: Aggregatibacter actinomycetemcomitans, Minimum bactericidal concentration, Minimum inhibitory concentration, Quercus infectoria
Copyright and License Information
© 2023 The Author(s).
This is an open access article distributed under the terms of the Creative Commons Attribution License (
http://creativecommons.org/licenses/by/4.0/), which permits unrestricted use, distribution, and reproduction in any medium, provided the original work is properly cited.
Introduction
Periodontal disease is a complex infection caused by the interaction between dental plaque and host immune response, leading to the loss of bone and periodontal tissues if it remains untreated.1 There are several bacterial etiologic factors, among which Agreggatibacter actinomycetemcomitans (Aa), Porphyromonas gingivalis (Pg), Prevotella intermedia (Pi), Bacteroides forsythus (Bf), Treponema denticola (Td), and Fusobacterium nucleatum (Fn) are the most important.2 Aa is a gram-negative non-motile facultative anaerobic Coccobacillus, which is the primary etiologic factor in aggressive periodontitis. Also, it has been found in the oral microbiota of patients with chronic periodontitis and periodontally healthy people.3-5 Aa has seven different serotypes (a to g), among which serotype b is most prevalent in an active periodontal lesion.6 This microorganism can remain in periodontal tissues after routine mechanical treatments and cause reinfection of periodontal pockets.7 Therefore, chemical agents, including systemic and local antibiotics, were suggested as adjuncts to mechanical therapies in the late 1970s.7
Chlorhexidine (CHX), known as the most effective local antimicrobial mouthwash, is vastly used to prevent and treat periodontal diseases.8 Some adverse effects, including discoloration of teeth, composite restorations, burning sensation of the tongue, oral mucosa, temporary taste disturbances, sensitivity, allergic reactions, and in some formulations, nausea and vomiting, have been reported.2,9 An increasing rate of antimicrobial resistance and its high cost has led clinicians to use other natural alternatives with minimal side effects, including active peptides, long-chain aldehydes, phenol, ethanol, chloroform, and methanol which have significantly positive therapeutic effects on bacterial, fungal, and viral infections, as well.10,11
Galls of Quercus infectoria (Qi) are a herbal product obtained from an evergreen bush with the same name, traditionally grown in Greece, western Asia, Iran, and Syria.12-16 It has antibacterial, anti-fungal, anti-viral,17 anti-inflammatory, and analgesic effects,18 helping to control diseases like diabetes, parkinsonism, dysentery, internal hemorrhage, gonorrhea, impetigo, and menorrhagia, with wound-healing effects. It is also an effective local anesthetic and antioxidant agent.19-23 The most significant agents in this product are tannins (50%‒70%) with antimicrobial properties,24,25 phenolic and flavonoid compounds (2-4 %) like gallotannic acid, gallic acid, and ellagic acid with antibacterial, antioxidant, and anti-viral properties.24,26-28
Several studies have evaluated the effects of Qi galls’ extract on oral pathogens and proved its positive effects on S. mutans, S. salivarius, Pg, Fn,24 S. mutans, S. sanguis,1 E. faecalis,29 and C. albicans.25,26,30,31 Basri & Fan32 and Priya et al33 examined aqueous/acetone and methanol extracts of Qi galls on some bacteria and found S. aureus as the most sensitive genus to it. Basri et al24 evaluated the effect of aqueous and acetone extracts of Qi galls on some oral bacteria. S. salivarius and Pg were the most sensitive Gram-positive and negative species, respectively, while the most inhibitory effect was observed with Gram-positive microorganisms. Also, the minimal inhibitory concentration (MIC) and minimal bactericidal concentration (MBC) were reported to be the same for both methanol and acetone extracts.24 These findings were confirmed by a study by Lamba et al,34 which showed its inhibitory effects on Fn, macrophages, and PMNs. Mohammadi-Sichani et al35 compared the ethanol, methanol, and acetone extracts of Qi galls on S. mutans and reported that the acetone extract had the most significant antibacterial effect.
However, no study has evaluated the antibacterial effects of Qi galls on Aa as one of the most critical Gram-negative periodontal pathogens. Also, its impact in terms of MIC and MBC is still unclear. Therefore, the present study aimed to investigate the antibacterial effects of hydroalcoholic extract of Qi galls on Aa to benefit from this valuable medicinal herb in producing mouthwashes or other antibacterial oral products with herbal origin, improving oral hygiene and preventing infectious periodontal diseases and their recurrence.
Methods
This in vitro study was carried out in 2020. Preparation of the plant and Qi galls’ extraction was accomplished in the Department of Traditional Medicine, Tehran University of Medical Sciences, Tehran, Iran, and the antibacterial activity was evaluated in the Microbiology Department, Shahid Beheshti University of Medical Sciences, Tehran, Iran.
Preparation of the plant and extraction
The plant extract was prepared by the maceration technique using distilled water/alcohol (70/30) as the solvent after soaking for 24 hours. The mixture was then filtered using the Whatman filter paper #1. The filtered mixture was thickened in the rotary evaporator device and kept under the biological hood until the rest of the solvent evaporated. Finally, the thoroughly dried extract was stored in a closed sterile container out of light in the refrigerator. The extract’s 20-mg/mL solution was prepared using dimethyl sulfoxide (DMSO) solvent when needed.
Microorganism
The bacterial species used in the present study was a gram-negative facultative anaerobe, Aggregibacter actinomycetemcomitans (Aa), Jp2nov99, which was cultured and kept in the microbial collection of the microbiology laboratory in a microaerophilic environment at 5%–10% CO2 and 37 °C in the Microbiology Department of Shahid Beheshti University of Medical Sciences.
Evaluation of the antibacterial activity
The agar-well diffusion and broth microdilution methods were used to evaluate the antibacterial activity of the hydroalcoholic extract of Qi to determine the MIC and MBC values for Aa.
Agar well diffusion
According to the Clinical Laboratory Standard Institute (CLSI) protocol, a bacterial suspension of 0.5 standard McFarland turbidity was prepared using physiologic serum36 so that the estimated number of bacterial cells would be 1.5 × 104 CFU/mL, and the optical density (OD) at 625 nm would be 0.08–0.13. Then, a sterile swab was used to apply a bacterial lawn from the bacterial suspension on the Mueller-Hinton agar culture medium (Merck, Germany). Afterward, 8-mm-diameter wells were produced in the agar gel using a sterile Pasteur pipette. Different concentrations (0.08, 0.15, 0.3, 0.625, 1.25, 2.5, 5, and 10 mg/mL) of the Qi extract were prepared from the 20-mg/mL solution, and 20 µL of each was administered in each agar well. 20 µL of 0.2% chlorhexidine and 20 µL of doxycycline solution (12.5 mg/mL) (Mast, UK) were applied in wells as the positive controls, and 20 µL of DMSO was applied as the negative control.
Agar plates were placed in the anaerobic jar with the GazPak A and kept in a 37 °C incubator. After 24 hours, the plates were retrieved from the jar, and the inhibition zone diameters around each well were measured in mm (Figures 1 and 2). Measurements were repeated in triplicate, and their mean values were reported for case and control groups.

Figure 1.
Placing the anaerobic jar in the incubator at 37 °C
.
Placing the anaerobic jar in the incubator at 37 °C
Figure 2.
The inhibition zone diameter in the agar well diffusion assay of (a) Qi extract, (b) chlorhexidine and doxycycline
.
The inhibition zone diameter in the agar well diffusion assay of (a) Qi extract, (b) chlorhexidine and doxycycline
Broth microdilution
As mentioned above, an 0.5 McFarland standard solution of the Aa bacterial suspension was prepared according to CLSI protocol.36 Then, 100 µL of Mueller-Hinton broth was applied to each well in a 96-well plate, followed by adding 100 µL of the 20-mg/mL solution of the Qi extract into the first well. Next, 100 µL of the solution from the first well was mixed in the second well using the sampling technique (pipetage), and this was repeated in the last well so that the concentration of the Qi extract in each well was equal to half of its prior concentration. Finally, 10 µL of 0.5 McFarland standard solution of the Aa bacterial suspension, diluted to 1/20, was added to each well. The same steps were taken with the 100 µL of the 0.2% CHX solution and the 100 µL of the 0.512-mg/mL doxycycline solution in the second and third rows of the plate, respectively, as positive control groups. In the other row, the culture medium, containing only bacterial suspension, and in the last row, the culture medium, containing different concentrations of the extract, were applied to ensure their wholesome. Then, the 96-well plates in the anaerobic jar with the GazPak A were kept in a 37 °C incubator for 24 hours. After incubation, the last clear well was determined for reading the MIC value. To determine the MBC value, an agar culture was made from each of the wells before and after the well was determined as the MIC and incubated in an anaerobic jar overnight. The last clear concentration of the Qi extract with no bacterial growth was determined as the MBC value (Figure 3). The trial was repeated three times, and mean values were reported.

Figure 3.
The MIC and MBC of (a) Qi extract, (b) chlorhexidine, and (c) doxycycline on Aa in broth microdilution assay following the culture on blood agar well plate
.
The MIC and MBC of (a) Qi extract, (b) chlorhexidine, and (c) doxycycline on Aa in broth microdilution assay following the culture on blood agar well plate
Statistical analysis
Aa’s inhibition zone diameters in the test and the control groups in the agar well diffusion method were measured in millimeters and analyzed with one-way ANOVA using SPSS 21. In addition, the means of the inhibition zone diameters of the microorganism, in the presence of Qi galls and CHX, were compared by the Tukey test. Mean values were considered significant when P value was < 0.05.
Results
Mean values of the inhibition zone diameters of Aa in plates containing the hydroalcoholic extract of Qi galls were measured at 10.33, 12.83, and 16.83 mm for the concentrations of 2.5, 5, and 10 mg/mL, respectively. There was no inhibition zone in plates containing concentrations of < 2.5 mg/mL of the extract. Also, the mean value for the diameter of the inhibition zone in plates containing 0.2% CHX was 17.13 mm, with 13.13 mm for doxycycline (Table 1). The mean values of MIC and MBC for both the test and control groups are reported in Table 2.
Table 1.
Comparison of the inhibition zone diameters obtained from the groups (in mm)
|
|
|
Experiment repetition
|
|
|
|
First
|
Second
|
Third
|
| Tested materials |
Qi extract (10 mg/mL) |
17 |
16.5 |
17 |
|
Qi extract (5 mg/mL) |
13 |
12.5 |
13 |
|
Qi extract (2.5 mg/mL) |
10 |
11 |
10 |
|
Qi extract (1.25 mg/mL) |
- |
- |
- |
|
Qi extract (0.625 mg/mL) |
- |
- |
- |
|
Qi extract (0.31 mg/mL) |
- |
- |
- |
|
Qi extract (0.15 mg/mL) |
- |
- |
- |
| CHX gluconate (0.2%) |
17 |
17.5 |
16.9 |
| Doxycycline (30 µg) |
13 |
12.9 |
13.5 |
| DMSO |
- |
- |
- |
Table 2.
Comparison of the MIC and MBC obtained from the groups
|
Microorganism
|
MIC (mg/mL)
|
MBC( mg/mL)
|
Qi
extract
|
CHX
|
Doxycycline
|
Qi
extract
|
CHX
|
Doxycycline
|
Aggregatibacter actinomycetemcomitans
(JP2 NOV99) |
2.5 |
0.0039 |
0.002 |
2.5 |
0.0078 |
0.004 |
Pair-wise comparisons of mean values for the inhibition zone diameter by the Tukey test revealed almost comparable values in all the groups with different concentrations of the extract and 0.2% CHX, except for the concentrations of 2.5 and 5 mg/mL of the extract, which was significantly less than 0.2% CHX (P < 0.05).
Discussion
Recently, the application of various herbal extracts with antimicrobial properties as an oral rinse has attracted the attention of clinicians and periodontal patients, considering the adverse reactions related to chemical mouthwashes.2,9,37,38 Some herbal compounds like Qi galls have been shown to have high efficiency, with antimicrobial, anti-inflammatory, anti-viral, analgesic, anti-pyrogenic, and antioxidant properties. They are also safe, inexpensive, and traditionally well-accepted.37-40 Therefore, the present study evaluated the potential antimicrobial effects of hydroalcoholic extract of Qi galls on one of the most critical periodontal pathogens, Aa, through agar well diffusion and broth microdilution techniques, which have not been studied before to our knowledge.
The present study showed the antimicrobial effect of hydroalcoholic extract of Qi galls on Aa, which can be attributed to some active compounds like phenolics, flavonoids, tannic acid, catechol, rosmarinic acid, pyrogallol, and gallic and ellagic acids, with strong antibacterial, anti-fungal, and antioxidant characteristics.24,26-28,41 As several studies have shown, the absolute content of tannins in any form of Qi galls extract is high.24,27-30,34,35,41 Therefore, this chemical compound is believed to be the main active element responsible for its antimicrobial activity.25,26,32 Tannin is a phenolic compound soluble in water and acetone and is precipitated by proteins.32,42-44 Recently, a promising aspect in the antibacterial mechanism of Qi galls’ extract has been proposed to be the neutralization of the virulence factors, and the quorum sensing in Pseudomonas isolated from burn ulcers can inhibit the formation and maturation of the bacterial plaque, especially in the oral cavity.19
Several studies on the effects of Qi galls’ extract on some microorganisms have shown that the antibacterial effects of alcoholic and acetone extracts and the antioxidant activity of the aqueous extract are more significant than other solvents.24-26,28,43-45 Also, the antibacterial effects of purified compounds of this medicinal herb will increase if mixed with other antioxidant agents.45 Nur Syukriah et al46 showed that the greatest amounts of bioactive components in Qi galls would be extracted if aqueous (80.3%), 70% methanol (74.34%), or 70% ethanol (71.44%) solvents are used. In contrast, the 100% acetone solvent showed the least favorable results, consistent with Mustafa et al,47 Tayel et al,41 and Wan Nor Amilah et al,42 who observed the more efficient extraction of bioactive agents in polarized solvents, leading to higher amounts of gallic and tannic acid in the final aqueous extract.46 Therefore, applying both aqueous and alcoholic solvents while preparing the extract of Qi galls will lead to a significantly higher antibacterial effect, which was the main reason for choosing this solvent in our study. Therefore, the hydroalcoholic extract of Qi galls is widely used, and its polarity has been modified.
According to other studies, Qi galls’ extract has more antibacterial activity against Gram-positive bacteria than Gram-negative ones, probably due to differences in their cell wall structure. In Gram-positive bacteria, the cell wall is made up of peptidoglycans without any outer membrane, making them very vulnerable. In contrast, the outer membrane in Gram-negative bacteria consists of a complex hydrophobic lipopolysaccharide which acts as a strong barrier against any morphological changes in the cell wall.24,25,32,34,41,42,44 Comparing our results to those reported by Nagesh et al29 confirmed this and will explain the higher MIC and MBC values for Aa compared to other Gram-positive bacteria.
In the present study, the highest mean diameter for the inhibition zone of Aa was 16.83 mm for 10% concentration of Qi extract, almost similar to that of 0.2% CHX and close to that of Pg and Fn in the study by Basri et al.24 The mean value for MIC and MBC for Qi extract in this study was 2.5 mg/mL and significantly higher than that of 0.2% CHX. This difference can be explained by the unique characteristics and diatonic nature of CHX, which enables its rapid, strong, and long-term bonding to surface proteins in Gram-negative bacteria, which maintains its antimicrobial and bacterial agglutinating effects for at least 12 hours in fluid environments like the oral cavity.48 On the other hand, differences in the effective concentration for both Qi extract and CHX, applied in this study, can explain such a significant discrepancy in their results. It is not unlikely that some changes in the water/ethanol proportion or applying other solvents like methanol or acetone would result in lower values of MIC and MBC for the Qi extract. Since no other study is available on the antibacterial effects of Qi extract on Aa, it is impossible to compare our results to similar investigations; however, its acceptable effects on other common oral bacteria or other periodontal pathogens have been well established.
Vermani and Prabhat28 studied the antibacterial effects of Qi extract with different solvents on some oral resident bacteria and reported the highest antibacterial value for the methanol extract on S. sanguis. In a similar study, Lamba et al34 showed the bacteriostatic effect of methanol and acetone Qi extracts on S. salivarius and Pg and the bactericidal effect on Fn. In a study by Basri et al,24 MIC and MBC values for methanol and acetone Qi extracts against Fn was 0.31 mg/mL, MIC for both methanol and acetone Qi extracts against Pg was 0.63 mg/mL, and MBC for methanol and acetone Qi extracts against Pg was 1.25 and 2.5 mg/mL, respectively. On the other hand, the mean diameter of the inhibition zone for gram-negatives like Pg and Fn was 18–19 mm, which is far less than that for gram-positive bacteria and approximately close to that of the present study, which was 17 mm.
Altogether, discrepancies in the antibacterial effects of Qi extract observed in several studies can probably be attributed to different compounds in the fresh herb caused by different geographical growing conditions, the degree of local humidity, the type of solvent, and the different extraction techniques.25,28,45 Also, tested concentrations in the broth microdilution assay and the studied microbial species would be a good reason for these controversies. According to Chusri and Voravuthikunchai,49 pure fractions of Qi, like ethyl acetate and its other principal contents like gallic acid and tannic acid, show a favorable MIC against MRSA, which were 0.06, 0.06, and 0.13 mg/mL, respectively. Therefore, further investigations on the antibacterial effects of the Qi extract purified components and comparing it to that of 0.2% CHX as a gold standard seem to be necessary for understanding the antibacterial mechanisms of this valuable herbal medicine.
Considering the observed antibacterial effects of Qi extract on Aa in the present study, it is highly suggested to extract the effective components of the whole herb to make further assessments with different solvents in the future. Also, other in vitro studies, including the evaluation of cytotoxicity and mutagenicity and its effects on dental plaque biofilm models, are prerequisites for formulating mouthwashes and local delivery agents from Qi for clinical use.
Conclusion
Hydroalcoholic extracts of Qi may be proper alternatives for chemical antiseptics to treat periodontal disease. Additional studies can further clarify the efficacy of this extract as a mouthwash or a local delivery system to eliminate periodontal biofilms.
Acknowledgments
This work was supported by the Dental Research Center, Research Institute of Dental Sciences, School of Dentistry, Shahid Beheshti University of Medical Sciences, Tehran, Iran, with the close contribution of the Department of Traditional Medicine, School of Persian Medicine, Tehran University of Medical Sciences, Tehran, Iran. The authors would like to thank all the technical and scientific support of all technicians and clinicians in both centers. Also, the authors kindly appreciate Dr. Mahshid Namdari for statistical support.
Availability of Data
The data used to support the findings of this study are available from the corresponding author upon request.
Competing Interests
The authors declare no known competing and financial interests or personal relationships that could have influenced the work reported in this paper.
Ethical Approval
This cross-sectional study was approved by the Ethics Committee of the Dental School, Shahid Beheshti University of Medical Sciences, Tehran, Iran (IR.SBMU.RIDS.1396.498).
Funding
This study was performed in Shahid Beheshti University of Medical Sciences.
References
- Prasad D, Kunnaiah R. Punica granatum: a review on its potential role in treating periodontal disease. J Indian Soc Periodontol 2014; 18(4):428-32. doi: 10.4103/0972-124x.138678 [Crossref] [ Google Scholar]
- Batista AL, Lins RD, de Souza Coelho R, do Nascimento Barbosa D, Moura Belém N, Alves Celestino FJ. Clinical efficacy analysis of the mouth rinsing with pomegranate and chamomile plant extracts in the gingival bleeding reduction. Complement Ther Clin Pract 2014; 20(1):93-8. doi: 10.1016/j.ctcp.2013.08.002 [Crossref] [ Google Scholar]
- Karched M, Furgang D, Sawalha N, Fine DH. Rapid identification of oral isolates of Aggregatibacteractinomycetemcomitans obtained from humans and primates by an ultrafast super convection based polymerase chain reaction. J Microbiol Methods 2012; 89(1):71-5. doi: 10.1016/j.mimet.2012.01.016 [Crossref] [ Google Scholar]
- Fine DH, Patil AG, Velusamy SK. Aggregatibacteractinomycetemcomitans (Aa) under the radar: myths and misunderstandings of Aa and its role in aggressive periodontitis. Front Immunol 2019; 10:728. doi: 10.3389/fimmu.2019.00728 [Crossref] [ Google Scholar]
- Mahalakshmi K, Krishnan P, Chandrasekaran SC. Detection of Aggregatibacteractinomycetemcomitans leukotoxin and fimbria-associated protein gene genotypes among periodontitis patients and healthy controls: a case-control study. Dent Res J (Isfahan) 2018; 15(3):185-90. [ Google Scholar]
- van der Reijden WA, Bosch-Tijhof CJ, van der Velden U, van Winkelhoff AJ. Java project on periodontal diseases: serotype distribution of Aggregatibacteractinomycetemcomitans and serotype dynamics over an 8-year period. J Clin Periodontol 2008; 35(6):487-92. doi: 10.1111/j.1600-051X.2008.01218.x [Crossref] [ Google Scholar]
- Newman MG, Takei H, Klokkevold PR, Carranza FA. Newman and Carranza’s Clinical Periodontology E-Book. Elsevier Health Sciences; 2018. p. 324-30.
- Ahuja S, Dodwad V, Kukreja BJ, Mehra P, Kukreja P. A comparative evaluation of efficacy of Punica granatum and chlorhexidine on plaque and gingivitis. J Int Clin Dent Res Organ 2011; 3(1):29-32. doi: 10.4103/2231-0754.115776 [Crossref] [ Google Scholar]
- Chinsembu KC. Plants and other natural products used in the management of oral infections and improvement of oral health. Acta Trop 2016; 154:6-18. doi: 10.1016/j.actatropica.2015.10.019 [Crossref] [ Google Scholar]
- Mahdi SS, Ibrahim LM, Ali WM. Antibacterial effect of aqueous and alcoholic propolis extracts on Aggregatibacteractinomycetemcomitans in patients with chronic periodontitis (an in-vitro study). J Baghdad Coll Dent 2015; 27(4):115-8. [ Google Scholar]
- Safary A, Motamedi H, Maleki S, Seyyednejad SM. A preliminary study on the antibacterial activity of Quercus brantii against bacterial pathogens, particularly enteric pathogens. Int J Botany 2009; 5(2):176-80. doi: 10.3923/ijb.2009.176.180 [Crossref] [ Google Scholar]
- Imtiyaz S, Ali SJ, Tariq M, Chaudhary SS, Aslam M. Oak galls: the medicinal balls. J Pharm Sci Innov 2013; 2(1):18-21. [ Google Scholar]
- Ahmad W. Ethnopharmacology of Quercus infectoria galls: a review. Hippocratic J Unani Med 2016; 11(3):105-8. [ Google Scholar]
- Ahmad W, Zeenat F, Hasan A, Abdullah A, Nargis A, Tarannum T. Mazu (Quercus infectoria, Oliv)-an overview. Indian J Unani Med 2011; 4(1):17-22. [ Google Scholar]
- Rina R, Rafiquzzaman M, Hasmah A. Spectrophotometric determination of total phenol and flavanoid content in Manjakani (Quercus infectoria) extracts. Health Environ J 2011; 2(1):9-13. [ Google Scholar]
- Ma S, Qin H, Jiang M, Wang J, Wang W, Guo G. Identification and comparison of tannins in gall of Rhus chinensis Mill. and gall of Quercus infectoria Olivby high-performance liquid chromatography-electrospray mass spectrometry. J Chromatogr Sci 2020; 58(5):403-10. doi: 10.1093/chromsci/bmz096 [Crossref] [ Google Scholar]
- Sawangjaroen N, Sawangjaroen K, Poonpanang P. Effects of Piper longum fruit, Piper sarmentosum root and Quercus infectoria nut gall on caecal amoebiasis in mice. J Ethnopharmacol 2004; 91(2-3):357-60. doi: 10.1016/j.jep.2004.01.014 [Crossref] [ Google Scholar]
- Fan SH, Ali NA, Basri DF. Evaluation of analgesic activity of the methanol extract from the galls of Quercus infectoria (Olivier) in rats. Evid Based Complement Alternat Med 2014; 2014:976764. doi: 10.1155/2014/976764 [Crossref] [ Google Scholar]
- Ahmed AA, Salih FA. Quercus infectoria gall extracts reduce quorum sensing-controlled virulence factors production and biofilm formation in Pseudomonas aeruginosa recovered from burn wounds. BMC Complement Altern Med 2019; 19(1):177. doi: 10.1186/s12906-019-2594-5 [Crossref] [ Google Scholar]
- Jalalpure SS, Patil MB, Alagawadi KR. Wound healing activity of the galls of Quercus infectoria Olivier. J Nat Remedies 2002; 2(1):54-8. doi: 10.18311/jnr/2002/345 [Crossref] [ Google Scholar]
- Darogha SN. Antibacterial activity of Quercus infectoria extracts against bacterial isolated from wound infection. Kirkuk University Journal-Scientific Studies 2009; 4(1):20-30. doi: 10.32894/kujss.2009.40787 [Crossref] [ Google Scholar]
- Chokpaisarn J, Chusri S, Amnuaikit T, Udomuksorn W, Voravuthikunchai SP. Potential wound healing activity of Quercus infectoria formulation in diabetic rats. PeerJ 2017; 5:e3608. doi: 10.7717/peerj.3608 [Crossref] [ Google Scholar]
- Umachigi SP, Jayaveera KN, Ashok Kumar CK, Kumar GS, Vrushabendra Swamy BM, Kishore Kumar DV. Studies on wound healing properties of Quercus infectoria. Trop J Pharm Res 2008; 7(1):913-9. doi: 10.4314/tjpr.v7i1.14677 [Crossref] [ Google Scholar]
- Basri DF, Tan LS, Shafiei Z, Zin NM. In vitro antibacterial activity of galls of Quercus infectoria Olivier against oral pathogens. Evid Based Complement Alternat Med 2012; 2012:632796. doi: 10.1155/2012/632796 [Crossref] [ Google Scholar]
- Nouri F, Raoofi A, Dadfar S. Antifungal activity of Lavandula angustifolia and Querguesinfectoria extracts in comparison with nystatin on Candida albicans. Avicenna J Clin Med 2016; 23(2):172-8. [ Google Scholar]
- Baharuddin NS, Abdullah H, Abdul Wahab WN. Anti-Candida activity of Quercus infectoria gall extracts against Candida species. J Pharm Bioallied Sci 2015; 7(1):15-20. doi: 10.4103/0975-7406.148742 [Crossref] [ Google Scholar]
- Wan Abd Wahab W, Abd Rahman N, Yahaya ML, Baharuddin NS, Noor Jamil NI. Antimicrobial effects of Quercus infectoria gall extract on the cell morphology of Streptococcus agalactiae, Proteus vulgaris and Candida albicans. Malays J Microbiol 2017; 13(1):13-9. doi: 10.21161/mjm.90916 [Crossref] [ Google Scholar]
- Vermani A, Prabhat N. The potential activity of galls of Quercus infectoria Oliv: as antibacterial agent against dental pathogens. J Indian Bot Soc 2010; 89(1-2):15-8. [ Google Scholar]
- Nagesh L, Sivasamy S, Muralikrishna KS, Bhat KG. Antibacterial potential of gall extract of Quercus infectoria against Enterococcus faecalis-an in vitro study. Pharmacogn J 2012; 4(30):47-50. doi: 10.5530/pj.2012.30.9 [Crossref] [ Google Scholar]
- Magbool FA, Elnima EI, Shayoub ME, Hussien S. Antifungal potential of Quercus infectoria galls against candida albicans-an invitro study. European J Biomed Pharm Sci 2018; 5(2):22-7. [ Google Scholar]
- Tayel AA, El-Tras WF, Abdel-Monem OA, El-Sabbagh SM, Alsohim AS, El-Refai EM. Production of anticandidal cotton textiles treated with oak gall extract. Rev Argent Microbiol 2013; 45(4):271-6. doi: 10.1016/s0325-7541(13)70036-1 [Crossref] [ Google Scholar]
- Basri DF, Fan SH. The potential of aqueous and acetone extracts of galls of Quercus infectoria as antibacterial agents. Indian J Pharmacol 2005; 37(1):26-9. doi: 10.4103/0253-7613.13851 [Crossref] [ Google Scholar]
- Priya PS, Sasikumar JM, Gowsigan G. Antibacterial activity of methanol extract of Rutachalapensis (L), Quercus infectoria (Oliver) and Canthium parviflorum (Lam). Anc Sci Life 2009; 29(2):28-31. [ Google Scholar]
- Lamba M, Jithendra K, Singh S, Sinha A. Quercus infectoria galls: herbal future for treating gingival diseases. J Periodontal Med Clin Pract 2016; 3:41-4. [ Google Scholar]
- Mohammadi-Sichani M, Karbasizadeh V, Dokhaharani SC. Evaluation of biofilm removal activity of Quercus infectoria galls against Streptococcus mutans. Dent Res J (Isfahan) 2016; 13(1):46-51. doi: 10.4103/1735-3327.174708 [Crossref] [ Google Scholar]
- Satlin MJ, Lewis JS, Weinstein MP, Patel J, Humphries RM, Kahlmeter G. Clinical and Laboratory Standards Institute and European Committee on Antimicrobial Susceptibility Testing Position Statements on Polymyxin B and Colistin Clinical Breakpoints. Clin Infect Dis 2020; 71(9):e523-e9. doi: 10.1093/cid/ciaa121 [Crossref] [ Google Scholar]
- Biswas G, Anup N, Acharya S, Kumawat H, Vishnani P, Tambi S. Evaluation of the efficacy of 02% chlorhexidine versus herbal oral rinse on plaque induced gingivitis-a randomized clinical trial. J Nurs Health Sci 2014; 3(2):58-63. doi: 10.9790/1959-03255863 [Crossref] [ Google Scholar]
- Salam R, Sarker BK, Haq MR, Khokon JU. Antimicrobial activity of medicinal plant for oral health and hygiene. Int J Nat Soc Sci 2015; 1(2):1-12. [ Google Scholar]
- Pentapati KC, Kukkamalla MA, Siddiq H, Sabnis N. Effectiveness of novel herbal dentifrice in control of plaque, gingivitis, and halitosis - randomized controlled trial. J Tradit Complement Med 2020; 10(6):565-9. doi: 10.1016/j.jtcme.2019.06.006 [Crossref] [ Google Scholar]
- Palombo EA. Traditional medicinal plant extracts and natural products with activity against oral bacteria: potential application in the prevention and treatment of oral diseases. Evid Based Complement Alternat Med 2011; 2011:680354. doi: 10.1093/ecam/nep067 [Crossref] [ Google Scholar]
- Tayel AA, El-Sedfy MA, Ibrahim AI, Moussa SH. Application of Quercus infectoria extract as a natural antimicrobial agent for chicken egg decontamination. Rev Argent Microbiol 2018; 50(4):391-7. doi: 10.1016/j.ram.2017.12.003 [Crossref] [ Google Scholar]
- Wan Nor Amilah WA, Masrah M, Hasmah A, Noor Izani NJ. In vitro antibacterial activity of Quercus infectoria gall extracts against multidrug resistant bacteria. Trop Biomed 2014; 31(4):680-8. [ Google Scholar]
- Hussein RA, Salih HA, Mehdi IR. Antibacterial activity of alcohol extract of Quercus infectoria Olivier. Al-Qadisiyah J Pure Sci 2015; 20(4):1-9. [ Google Scholar]
- Leela T, Satirapipathkul C. Studies on the antibacterial activity of Quercus infectoria galls. In: International Conference on Bioscience, Biochemistry and Bioinformatics. Singapore: IACSIT Press; 2011.
- Ebadi Fathabad A, Shariatifar N, Mardani K, Mohammadpourfard I. Study on antibacterial and antioxidant activity of oak gall (Quercus infectoria) extracts from Iran. Int J Curr Sci 2015; 14:44-50. [ Google Scholar]
- Nur Syukriah AR, Liza MS, Harisun Y, Fadzillah AA. Effect of solvent extraction on antioxidant and antibacterial activities from Quercus infectoria (Manjakani). Int Food Res J 2014; 21(3):1031-7. [ Google Scholar]
- Mustafa H, Ismail N, Wan Nor Amilah WA. Anti-microbial activity of aqueous Quercus infectoria gall extract against pathogenic Leptospira. Malays J Med Sci 2018; 25(4):42-50. doi: 10.21315/mjms2018.25.4.4 [Crossref] [ Google Scholar]
- Balagopal S, Arjunkumar R. Chlorhexidine: the gold standard antiplaque agent. J Pharm Sci Res 2013; 5(12):270-4. [ Google Scholar]
- Chusri S, Voravuthikunchai SP. Damage of staphylococcal cytoplasmic membrane by Quercus infectoria GOlivier and its components. Lett Appl Microbiol 2011; 52(6):565-72. doi: 10.1111/j.1472-765X.2011.03041.x [Crossref] [ Google Scholar]